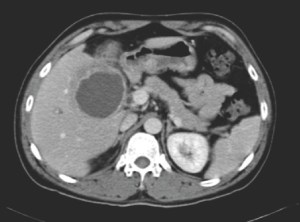
CT image of the abdomen

Clinical Vignette 5
The same young man from Myanmar mentioned in Vignette 4 was extensively worked up for his fever. Blood cultures were negative. A CT of his abdomen, however, showed the following lesion in his liver.
What is the most likely diagnosis and what test(s) would help to confirm it?
[Updated 1 November 2014]
The CT image shows a hypodense and rather regular structure in the liver. In this setting, the most likely diagnosis is amoebic liver abscess. There are a few ways to confirm this diagnosis, the simplest being a blood test for antibodies to Entamoeba histolytica – the causative organism. A biopsy of the wall of the abscess may also be performed under radiological guidance – amoeba can usually be seen on histopathology (but an aspirate of the pus is usually negative). Stool microscopy for amoebic cysts is not particularly helpful, as the test is not very sensitive (approximately 40% positive), and presence of the cysts is not conclusive proof that the abscess is caused by Entamoeba histolytica.
Treatment is with high-dose metronidazole. There is insufficient evidence to support or refute adjunctive percutaneous drainage of amoebic liver abscesses.